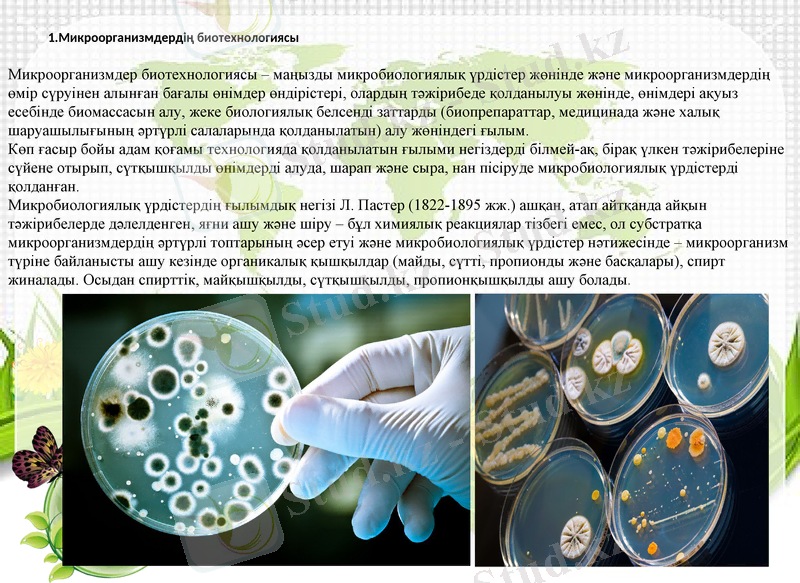
Slide 10

Биотехнологияның даму тарихы мен негізгі салалары



ҚАЗАҚСТАН РЕСПУБЛИКАСЫНЫҢ БІЛІМ ЖӘНЕ ҒЫЛЫМ МИНИСТРЛІГІ ӘЛ-ФАРАБИ АТЫНДАҒЫ ҚАЗАҚ ҰЛТТЫҚ УНИВЕРСИТЕТІ СӨЖ Тақырыбы: Биотехнологияның даму тарихы және салалары
Орындаған:
Факультет: Биология және биотехнология
Кафедра:
Тексерген:

Мазмұны
Кіріспе. Биотехнологияның даму тарихы
Негізгі бөлім. Биотехнологияның салалары
Өсімдіктер биотехнологиясы
Медициналық биотехнология
Экологиялық биотехнология
Өндірістік биотехнология
Иммундық биотехнология
Микроорганизмдер биотехнологиясы
Қорытынды
Пайдаланылған әдебиеттер

Биотехнология (bios - тіршілік; thechne-өнер, шеберлік; logos-ғылым) - тірі ағзалар мен биологиялық үрдістерді өндірісте пайдалану; экономикалық құнды заттарды алу үшін ген және жасуша деңгейінде өзгертілген биологиялық объектілерді құрастыру технологиялары мен пайдалану жөніндегі ғылым және өндіріс саласы.
Биотехнологияның негізгі объектісі - тірі жасушалар, атап айтқанда жануар, өсімдік текті жасушалар және микробтар немесе олардың биологиялық белсенді метаболиттері.
Алғаш рет «биотехнология» термині 1917 жылы Карл Эреки шошқаларды қант қызылшасымен қоректендіру кезінде олардың өнімдерінің жоғарылауы жасалған жұмыстарының нәтижесінде берілген.
Биотехнология ─ биологиялық процестердің өту заңдылықтарын терең зерттеп, ұғу арқасында биологиялық объектілердің қызметін пайдалану негізінде іске асырылатын қазіргі заманның өте тиімді де биік деңгейдегі технологиясы.

Биотехнологияның ашылуы, жасалуы және даму тарихы Биотехнологияның пайда болуымен даму тарихында ғылыми пән ретінде голланд ғалымы Е. Хаувинк 5 кезеңді ажыратты: 1. Пастер ғасырына дейінгі эра (1865ж. ) . Сыра, шарап, нан өнімдері және сыра ашытқыларын, ірімшік алғандаағы спирттік және сүт қышқылды ашытуды қолдану. Сірке қышқылын және ферментативті өнімдерді алу. 2. Пастер ғасырлық кезеңі(1866-1940 жж. ) - этанол, бутанол, ацетон, глицерин, органикалық қышқылдарды, вакциналарды өндіру. Канализациялық суды аэробты тазалау. Көмірсулардан азықтық ашытқыларды өндіру. 3. Антибиотиктер кезеңі (1940-1960 жж. ) - тереңдетілген ферментация жолымен пенициллин және басқа антибиотктерді алу. Өсімдік жасушаларын дақылдау және вирустық вакциналарды алу. Стероидтарлың микробиологиялық биотрансформациясы. 4. Меңгерілетін биосинтез кезеңі (1961-1975 жж. ) - микробты мунаттар көмегімен амин қышқылдарын өңдіру. Тазартылған ферменттік препараттар алу. Иммобилизацияланған ферменттерді және жасушаларды өадірістік қолдану. Канализацилық суларды анаэробты тазалау және биогаз алу. Бактериалды полисахаридтерді өндіру. 5. Жаңа биотехнология кезеңі (1973 ж. бастап) - биосинтез агенттерін алу мақсатында жасушалық және генетикалық инженерияны қолдану. Моноклоналды антиденелерді өндіретін будандарды, протопласттарды және меристемді дақылдарды будандастырып алу. Эмбриондарды трансплантациялау.

Биотехнология салалары
Өсімдіктер биотехнологиясы - ғылым мен өндірістің өсімдік органдары мен оларда жүретін биологиялық процестердің негізінде түбегейлі жаңа технологиялар құрып, адамға қажетті өнімдерді алуға мүмкіндік беретін жаңа саласы.
Өсімдіктер биотехнологиясы саласындағы алғашқы зерттеулерді 19 ғасырдың аяғында неміс ғалымдары К. Рехингер мен Х. Фехтинг жүргізді.
Негізгі бағыттары:
гендік және клеткалық инженерия
гаплоидты биотехнология
клондық көбейту
биологиялық активті заттар алу, фиторемедиация, гендік банк жасау, т. б.

Медициналық биотехнология
Биотехнологияның даму тарихының негізгі кезеңдерінің бірі - бұл антибиотиктердің ашылуы, олардың зертханалық жағдайда алу және өндірістік масштабта өндірілу кезеңі болады. Қазіргі уақытта денсаулық сақтаудың алғашқы мақсаты болып, жаңа антибиотиктердің, әсіресе табиғи қасиеті бар антибиотиктерді, сонымен қатар, тағам өнеркәсібінде және ветеринарияда өндіріп қолдану. Мәнісінде, антибиотиктер фармпрепараттарды тұтынуда және биотехнологиялық өндірілу көлемінде ең үлкен класс болып табылады.
Қазіргі медицинада гомональды препараттар (инсулин, соматотропин және т. б. ), биологиялық активті заттар (интерлейкиндер, интерферондар, қан плазмилогенінің белсендіргіші, антигемофильді фактор және т. б. ), генді инженериялық вакциналар (суббірліктің, пептидтік, «векторлық»), моноклоналды антиденелер негізінде диагностикумдар, нуклеин қышқылдарын анықтау үшін тест-жүйелер және т. б.
Фитопрепараттар (алкалоидтар, гликозидтер, стероидтар, эфирлік майлар және т. б. ), микробтық ферменттерді (стертокиназа, урокиназа, супероксиддисмутаза, әртүрлі амилазалар және протеазалар), полидекстрандарды қолдануы және өндірілуі кеңеюде.

Экологиялық биотехнология
Қоршаған ортаның экологиялық күйі - бұл әрбір мемлекет, бүкіл адам, қоғам үшін тұрақты үдемелі мәселе. Топырақтың, судың және ауаның ксенобиотиктермен, химиялық заттармен, сондай-ақ улы қосылыстармен, ауыр металдармен, пестицидтермен, коммуналдық қалдықтармен ластану қарқындылығын, биологиялық технология көмегін пайдалана отырып тоқтатуға болады.
Қоршаған ортада микроорганизмдердің барлық жерде болуы және олардың үлкен катаболизмдік потенциялының әсерінен, биосфераға түскен кез келген қосылыс түгелдей минералданады деп болжайтын (микробиологиялық үміттену) гипотеза, табиғаттағы заттар айналасындағы микроорганизмдердің негізгі шешуші ролінен шығады. Өкінішке орай, шындығында қоршаған ортаның антропогендік ластану динамикасы, микроорганиздердің пайдаланылуына қарағанда басымырақ болады.
Егер су қоймаларының және топырақтың, ірі мегаполистердің газдалуы, сұық және қатты қалдықтардың көп мөлшерде қалыптасуы әр қилы болса, онда табиғаттың генефондтың жеткіліксіздігі, көптеген биологиялық тапшылықтар аз көрініс табады, бірақ сонда да маңыздылығы іргелі.
Сондықтан, экологиялық биотехнологияның негізгі бағыттары деп санауға болады: өсімдік шаруашылығында, мал шаруашылығында және басқа салаларда жасанды заттардың орнына биопрепараттарды қолдану көлемі мен спектрінің кеңеюі; ластайтын элементтерді (пестицидтер, ауыр металдар, мұнай және мұнай өнімдерін) бұзу және активті бөліп алу жолымен қоршаған ортаны ремедиациялау; қатты коммуналды қалдықтарды, тұрып қалған сулардың тұнбасын пайдалану; топырақ гумусын, құрамын қалыпқа келтіру, нитрификациялау, су құбырларын өңдеу жолдарымен және адам денсаулығына, жануарларға және өсімдіктерге қауіпсіз биологиялық технологияларды өндірісте қолдану.
Бағалы жануарлар, өсімдіктер және микроорганизмдердің генефондын, биогеоценоздың бұзылған экологиясын қалпына келтіруде, биотехнологиялық амалдарды қолдану жолымен сақтау.

Өндірістік биотехнология
Халық шауашылығының әртүрлі салаларын қамтиды, өндірістік технологияның басты буыны болып, өндірістік микробиология табылады, себебі ірі биотехнологиялық өндіріс негізінде микробиологиялық үрдістер жатыр. Бұл өндірістік масштабта микробтық аминқышқылдары, антибиотиктерді, ферменттерді алу, инсектицидтер мен тыңайтқыштар ретінде микробты биомассаларды өндіру, қоректік ақуыздарды, этанол, биогаз, дәрумендер, органикалық қышқылдарды, полисахаридтерді өндіру, рекомбинантты ДНК технологиясы негізінде биологиялық белсенді заттар, гормондарды, адам ақуыздарын алу.
Өндірістік биотехнологияның өзі де тау металлургиясында орын алады. Бұл микроорганизмдер және ферменттердің көмегімен металдарды ерітілген күйде минералды концентраттар, кендерден бөліп алуға көмек беретін металлдар (микробиологиялық гидрометаллургия, металдарды бактериалды сілтілеу) биотехнологиясы. Мысалға, металдардың сульфидтерін ерітілген сульфатқа айналдыру жолы.
Мұнай өндіру саласында балластты көмірсутек-парафинді (балауызды) ыдырататын, мұнайды сұйылтатын және жер бетінде оның алынуын жеңілдететін микроорганизмдерді қолдану. Микроорганизмдер - мұнай ыдыратушылар, мұнай өнімдерімен ластанған топырақты және су қоймаларын тазартуға қолданылады. Қатты қалдықтардан биогазды (метан) алуда дамудың нағыз болашағы болып табылады, әсіресе мұнай өнімдерінің жетіспеушілігінің үдеуін есептесек.
Тағам және жеңіл өнеркәсіпте биотехнологияның өзіндік бағыттары бар: нан пісіру, ірімшік дайындау, сыра қайнату, шараптар мен шырындар дайындау, жүн өнімдерін тазалау, тері илеу және т. б.
Биоэлектроника - бұл ақпараттық технология аймағында, өлшеуіш- бақылайтын датчиктерді, сенсорлар ретінде биотехнологиялық жүйелерді қолдану.
Инженерлік энзимологиямен қатар, (биотехнологияда ферменттерді алу мен қолдану), протоинженерлік, (генетикалық деңгейде табиғи ақуыздар қасиетінің өзгеру технологиясы, жаңа ақуыздарды алу), қарқынды дамуда.

Иммундық биотехнология
Инфекциялық емес, сонымен қатар инфекциялық аурулурды емдеу және диагностикалау, алдын алу үшін көп мөлшерде иммунопрепараттарды бөліп алу қажеттілігі иммундық битехнологияның дамуымен тығыз байланысты.
Иммундық препараттар: дигностикумдар, вакциналар, иммундық сарысулар және моноклоналды антиденелердің кең спектрлерін жасау және өндіруге міндетті.
Вакциналар иммунопрофилактика үшін, кейде емдеу үшін қолданылады, себебі олар белсенді, жасанды иммунитетті қалыптастырады.
Диагностикумдар - иммуно-ферменттік талдамаларда аурулардың серологиялық диагностикасы үшін, комплемент байланыстыру реакциясында, басқа да иммунологиялық реакцияларда қажет.
Иммунды сарысулар инфекциялық аурулардың диагностикасына керек. Сондай ақ, олар емдік мақсатта жасанды пассивті иммунитетті жасау үшін қолданылады.
Биотехнология адам денсаулығын сақтау және нығайтуда, қоршаған орта ремедиациясын және табиғаттың экологиялық тепе-теңдігін ұстап тұруда өте маңызды.
Микроорганизмдердің биотехнологиясы
- Іс жүргізу
- Автоматтандыру, Техника
- Алғашқы әскери дайындық
- Астрономия
- Ауыл шаруашылығы
- Банк ісі
- Бизнесті бағалау
- Биология
- Бухгалтерлік іс
- Валеология
- Ветеринария
- География
- Геология, Геофизика, Геодезия
- Дін
- Ет, сүт, шарап өнімдері
- Жалпы тарих
- Жер кадастрі, Жылжымайтын мүлік
- Журналистика
- Информатика
- Кеден ісі
- Маркетинг
- Математика, Геометрия
- Медицина
- Мемлекеттік басқару
- Менеджмент
- Мұнай, Газ
- Мұрағат ісі
- Мәдениеттану
- ОБЖ (Основы безопасности жизнедеятельности)
- Педагогика
- Полиграфия
- Психология
- Салық
- Саясаттану
- Сақтандыру
- Сертификаттау, стандарттау
- Социология, Демография
- Спорт
- Статистика
- Тілтану, Филология
- Тарихи тұлғалар
- Тау-кен ісі
- Транспорт
- Туризм
- Физика
- Философия
- Халықаралық қатынастар
- Химия
- Экология, Қоршаған ортаны қорғау
- Экономика
- Экономикалық география
- Электротехника
- Қазақстан тарихы
- Қаржы
- Құрылыс
- Құқық, Криминалистика
- Әдебиет
- Өнер, музыка
- Өнеркәсіп, Өндіріс
Қазақ тілінде жазылған рефераттар, курстық жұмыстар, дипломдық жұмыстар бойынша біздің қор #1 болып табылады.



Ақпарат
Қосымша
Email: info@stud.kz